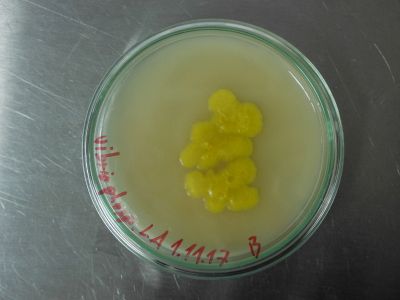

The digital lab-book
25. October
inoculated cooked cardboard with Pleurotus pegs.
31. October
starting to grow vibrio phosphoreum from a batch that was labelled Photobacterium phosp. and seemed to be inoculated somewhere in 2016. (the writing on the petri-dish was rendered unreadable)
cooked 100ml of LA-Medium and left it overnight in the fridge.
on plastic petri-dishes: I decided to use only glass-petri-dishes, as they give me the opportunity to sterilise medium inside the dishes, thus limiting to chances for contamination greatly. and they produce less waste, are to be recycled if broken, if not broken have a unlimited shelf life and usage time.
migrated the pleurotus from the plastic mushroom supermarket dish to a tupperware. no sign of growth.
1.November
Autoclaved two dishes filled with LA-Medium, one of the dishes filled up with water during the process, discarded and poured with leftover medium that has been in the autoclave, and inoculated with vibrio phosphoreum around 16.00. they should start to glow in 12-24 hours.
2.November
Pleurotus growth becomes apparent. vibrio phosp. still no luminescence. maybe the concentration of the the autoinducer is still to low in the medium. (Osamu Shimomura: Bioluminescence, Chemical Principles and Methods chapt. 2.7 p. 42 subchapt. Auto induction)
Euglena seem to spin when there is not enough light for them, rather an otherwise. Which makes perfect sense (appetitive behaviour) but somehow I thought it to be the other way round.
8. November
vibrio phosp. dish A shows signs of contamination, I assume due to autoclaving problems as mentioned above. still no luminescence, I am beginning to suspect them to be dark mutants (Osamu Shimomura: Bioluminescence, Chemical Principles and Methods chapt. 2.7 p. 43 subchapt. Formation of dark mutants) Pleurotus grow is, if, growing very slowly, planning to move on of the two pegs to another medium.
supplementary: vibrio phosp. opened jar A and shock it vigorously under the laminar hood, to get oxygen to the bacteria, which should aid glowing. no effect. the sample has to be discarded anyway.
9. November
Discarded jar A of vibrio phosp. due to high contamination. transferred on of the pleurotus pegs on malt medium. (Paul Stamets, The Mushroom Cultivator)
15. November
Pleurotus in malt-medium spawns cottony mycelium. The sample shows mild contamination. the tupperware sample still is, if growing very slowly but shows no signs of contamination. the temperature of the incubator is now 25.5
16.November Cooked and sterilised 1 Liter of Potato-Dextrose-Agar-Medium. Poured 5 petri-dishes, to be sterilised on friday. Still no luminescence in vibr. phosp.
17. November
sterilised and inoculated 3 petri dishes with Pleurotus strains from the peg on malt-medium. Transferred the original peg to one petri dish and kept one blank for controlling. All dishes are Potato-Dextrose-Agar-Medium. the tupperware pleurotus caught on in growing, but still is very restrained.
19. November
Pleurotus: all samples show good growth and no contamination. Cottony mycelium (typical for pleurotus ostreatus) is developing.

The peg jar looks strange though. I rolled the peg around in the dish on the 17th. Now the surface of the medium shows the tracks of this action. But the developing organism looks rather yeasty than mycely. 26.November
All Pleurotus samples look very promising. The F1 generation samples are thriving. No contamination at all. Very soon the production of spawn can begin. The peg sample is now all cottony mycelium. So no yeasts, just the look of them. Maybe there are more of this early stage structures in the sample, or it is minor contamination. The control blank shows no sign of contamination.
Inoculated on jar of LA-bacteria-medium with kirby and cabbage kimchi samples.
29. November
The kimchi jar shows no signs of growth, nor contamination. Nothing shows up under the microscope.
30. November Prepared rye for grain master according to Stamets.
1. December
Inoculated Grain Master G1. (2x 150g)